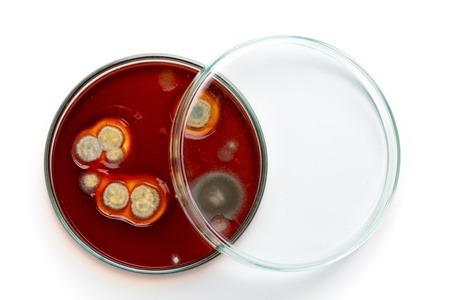

Jetzt neu: "Knöchel exquisit" Spannbettlaken mit höherem Steg 01.10.2025
Ein hochwertiges aber preisgünstiges Spannbettlaken für uns produziert in der Größe 180x200 bis 200x220 und in vielen Farben erhältlich für nur 69,- EUR

Wasserbetten sind im Sommer angenehm kühl und im Winter mollig warm - jederzeit ganz nach Bedarf individuell einstellbar.
Kurz zusammenfasst: „Gut Schlafen, erholt aufwachen und mit neuer Energie in den Tag starten“
Aber das Wasserbett bietet noch weitere Vorteile, wobei dem erholsamen Schlaf die wichtigste Rolle zukommt. Hier die weiteren Vorteile des Wasserbettes im Überblick:
Wasserbetten sind im Sommer kühl und im Winter warm. Das bedeutet, sie benötigen um in der kalten Jahreszeit in ein warmes Bett zu steigen, keine Heizdecken oder Bettflaschen mehr. Sie können das Wasserbett immer je nach Wetterlage auf die für Sie persönlich optimale Temperatur herauf- oder herunterregeln.
In einem warmen Bett verringert sich zudem die Einschlafzeit, da Sie nicht erst Ihr Bett selber "aufheizen" müssen. In heißen Nächten dagegen bietet das Wasserbett angenehme, niedrige Temperaturen.
Die Hygienebedingungen eines Wasserbettes sind nicht zu übertreffen, da Hautschuppen und Staub von der Wasserbettmatratze einfach abgewaschen, Bezüge und Auflage bei 60 oder 95° in der Waschmaschine gewaschen werden können. Damit schlafen Sie immer in einem sauberen und hygienischen Bett. Das bedeutet gerade für Allergiker die ideale Martratze - keine Milben bedeutet auch Verhinderung von Hausstauballergien.
Das ist mit keiner anderen Matratzenart möglich!

... sind oft für Pickel verantwortlich. Das lässt sich nachweisen, wenn man bevorzugt mit der einen Gesichtshälfte auf dem Kopfkissen schläft und Bakterien ins Kopfkissen gelangt sind. Dann entstehen vermehrt Pickel auf dieser Gesichtshälfte. Selbst intensive Reinigung der Haut führt nicht zur Abnahme der Pickel, da in der nächsten Nacht beim Schlafen die Bakterien wieder auf das Gesicht gelangen. Gerade in der Pubertät sollte zur Vermeidung von Akne oder zur Linderung der hervorgerufenen Beschwerden auf alle Fälle ein waschbares Kissen eingesetzt werden. Aber auch schlimmere Krankheiten wie Lungenentzündung können hervorgerufen werden. Sehr häufig sind Bakterien, aber auch Viren, Pilze und Parasiten die Verursacher. Mikrobiologen zufolge überleben immer mehr Bakterien selbst den Waschvorgang. Dieser Umstand lässt sich vor allem durch die niedrige Waschtemperatur erklären. Wäsche, die bei 40° C gewaschen wird, enthält 500 mal weniger Bakterien als vor der Wäsche. Wird die gleiche Wäsche bei 30° C gewaschen, enthält sie nur 10 mal weniger Bakterien als vor der Wäsche. Deshalb ist ein ausreichender Schutz erst ab einer Waschtemperatur von 60° gewährleistet.

... sind winzige Spinnentierchen, die zwischen 0,1 - 0,5 Millimeter groß sind. Sie bevölkern bevorzugt die Betten, weil dort Ihre Lebensbedingungen optimal sind. Die Milben finden im Bett ihre Lieblingsspeise, die Haut- und Haarschuppen. Eine Million Milben können sich von einem Gramm Schuppen eine Woche lang ernähren, und jeder Mensch verliert pro Nacht ungefähr 1,5 Gramm! Sie sind also garantiert nie allein im Bett. Die Allergene sind Eiweißstoffe, die sowohl in der Milbe als auch im Milbenkot vorkommen. Betten stellen für Milben einen optimalen Lebensraum dar. Durch nächtliche Schweiß- und Speichelabsonderung herrscht ein leicht feuchtes Milieu und es gibt reichlich Nahrung. Sie können nicht fliegen, doch werden sie durch die Luft verbreitet, wenn man Betten macht und die Kopfkissen aufschüttelt. Das Einatmen einer hohen Konzentration von Milbenkot kann sehr unterschiedliche allergische Äußerungen hervorrufen, doch betreffen sie vor allem die Atemwege und äußern sich meist durch Rhinitis (wiederholtes Niesen, verstopfte Nase, tränende Augen) oder Asthma. Deshalb stellt alleine die Waschbarkeit des Kopfkissens über 60° eine sichere Art dar, Milben im Kopfkissen zu vermeiden.
... können prinzipiell überall dort in Innenräumen vorkommen, wo die Luftfeuchtigkeit hoch ist. Aus diesem Grund ist das Kopfkissen ein bevorzugter Nährboden für Pilze, da durch den nächtlichen Schweiß- und Speichelfluss, ein warmes, feuchtes Biotop entsteht, das für die Vermehrung der Pilze notwendig ist. Die Pilze wachsen auf organischen Materialien, aber auch auf Kunststoffen. Die Allergene sind nicht die Pilze selbst, sondern die Sporen, die von den Pilzen zur Fortpflanzung in die Luft abgegeben werden. Solange unsere Körperabwehr uneingeschränkt funktioniert, wird sie mit den Pilzen fertig. Bei abwehrgeschwächten Menschen können jedoch Pilzerkrankungen entstehen, die lebensbedrohlich sind. Das gilt für Schimmelpilze, speziell für den Aspergillus, der in Baumwolle, Polstermöbeln, Schaumstoffmatratzen, Kissen seinen bevorzugten Lebensraum findet
Durch die angenehme Wärme kann sich IhreMuskulatur weit besser erholen, das hilft zu einem tieferen Schlaf. Auch muss der Kreislauf beim Schlafengehen das Bett nicht mehr vorher aufwärmen, sondern ist bereits optimal vorgeheizt. Somit wird ein schnelleres Einschlafen ermöglicht.
Sie können also völlig auf Heizdecken und Wärmflaschen verzichten!
Mit einem optimal individuell über die Wasserfüllmenge eingestelltem Wasserbett (Füllmenge) wird die Körperform ideal unterstützt, so dass keine Druckpunkten entstehen, sondern der Körper über das Körpergewicht vollflächig in die Matratze gedrückt und abgestützt wird. Durch diese gleichmäßige Druckverteilung kann sogar werdenden Mütter in einer Wasserbettmatratze ein erholsamer Schlaf während ihrer Schwangerschafts geboten werden.
Eine Wohltat für jeden, der unter Rücken- oder Gelenksschmerzen leidet.
Sicherlich ist der Anschaffungspreis einer Wasserbettmatratze nicht mit einer günstig hergestellten Kaltschaummatratze vergleichbar. Dafür hält eine Wasserbettmatratze durchschnittlich 3 mal so lange wie eine herkömmliche Matratze.
Langfristig lohnt sich also diese Investition, mal ganz abgesehen von den Vorteilen eines Wasserbettes.
Auch eine hochwertige Matratze sollte spätestens nach 5 Jahren getauscht werden, da sie durchgelegen ist und den Körper nicht mehr richtig unterstützt. In einem Wasserbett schlafen Sie auch nach 15 Jahren noch wie am ersten Tag, da es kein "Durchliegen" geben kann.
Als Langzeitinvestition gesehen, ist eine Wasserbettmatratze günstiger als eine normale Matratze.
Sie können jedes Bett zum Wasserbett umrüsten! Deshalb müssen Sie sich nicht von Ihrem gewohnten Bettgestell, das wahrscheinlich Bestandteil Ihrer Schlafzimmer-Einrichtung ist, trennen. Sie können trotzdem auf eine Wasserbettmatratze mit ihren vielen Vorteilen umsteigen wollen.
Wichtig ist, dass Ihr Bett in einer heute üblichen Größe gefertigt wurde. Selbstverständlich funktioniert das auch mit antiken Bettgestellen, wenn die Größe in etwa diese Vorraussetzungen erfüllt.
Wasserbett Zentrum Knöchel GmbH
Johann Dahlem Str.64, 63814 Mainaschaff
Öffnungszeiten:
Montag – Freitag von 10:00 bis 18:30 Uhr durchgehend
Samstag von 10:00 bis 15:30 Uhr durchgehend
Kontakt:
Fon: 0 60 21 / 4 42 94 0
Fax: 0 60 21 / 4 42 94 79
Mail: info@knoechel.net
Web: www.knoechel.net
Das Wasserbettzentrum Knöchel ist der Abfallentsorgung durch das "Duales System - Grüner Punkt" angeschlossen und wird im Verpackungsregister LUCIT unter der Nummer DE 30 717 515 141 geführt.
© Copyright 2016 Wasserbettzentrum Knöchel GmbH. Alle Rechte vorbehalten. Erstellt mit ERF-CMS und Shopmodul von Modulkonzept
Ein hochwertiges aber preisgünstiges Spannbettlaken für uns produziert in der Größe 180x200 bis 200x220 und in vielen Farben erhältlich für nur 69,- EUR
Von Montag – Freitag von 10:00 bis 18:30 Uhr durchgehend
und am Samstag von 10:00 bis 15:30 Uhr durchgehend
unter der Rufnummer
Für den Fall der Fall der Fälle:
Lesen Sie vor der Bestellung in unserem Shop unsere Shop-AGB und die Widerrufserklärung für Bestellungen in unserem Onlineshop.
Wenn Sie Probleme mit Ihrem Wasserbett haben und einen Fachmann benötigen, der eine Reparatur durchführt, Ihnen das Wasserbett umzieht, Matratzen oder Zubehör austauscht. Unser Kundendienst ist für Sie da.
In unserem Terminkalender sind alle wichtigen Termine eingetragen, so dass Sie sich gut darüber informieren können, wann wir Entlüftungsschulungen durchführen, auf Messen austellen oder zeitlich begrenzte Aktionsprogramme anbieten.
Wir möchten Ihnen das Onlineshopping bei uns einfach machen. Sie können deshalb bei uns per Bankeinzug mit SEPA-Mandat bezahlen oder mit Kreditkarte oder EC-Zahlung per PayPal. Auch Barzahlung bei Abholung ist für Sie möglich.


